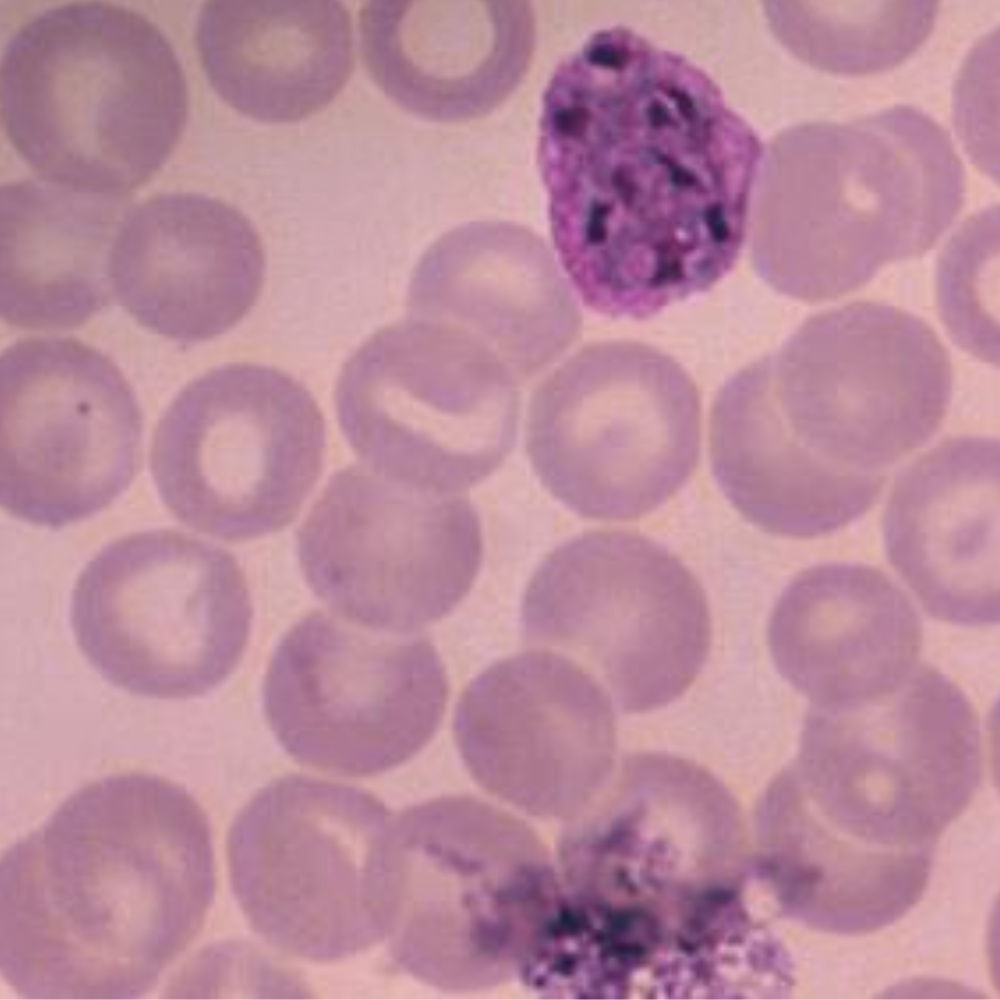

Impactful malaria science,
and the trailblazers leading the fight.
Impactful malaria science, and the trailblazers leading the fight.
The Johns Hopkins Malaria Minute summarizes the latest malaria research in 60 seconds and interviews the scientists behind the discoveries. Produced monthly by the Johns Hopkins Malaria Research Institute.
Using lasers and ultrasound, the ‘cytophone’ detects a key byproduct of all malaria parasites.
An innovative, non-invasive diagnostic tool that could revolutionize malaria testing, with the potential to be built into wearable devices.
Featuring: Sunil Parikh, Vladimir Zharov and Yap Boum.
How Comparative Genomics Can Help Find the Best Treatments for Malaria
‘Comparative genomics’ helps identify genes that can serve as targets for future drugs and vaccines.

First Reference Genome Sequence of P. vivax from Ethiopia
How DNA from a single patient in Ethiopia can shed light on the big picture of malaria – with Jane Carlton, Delenasaw Yewhalaw, and Francisco Callejas Hernandez.
and the trailblazers leading the fight.


